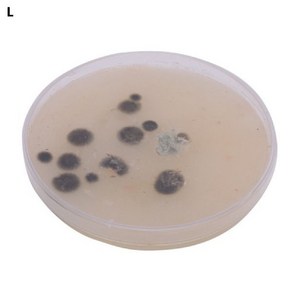

세균배양배지 만들기 SET (일반세균)
- 별점
- 5 (3)
- 가격
- 17,300₩
- 배송요금
- 2,500 (수요일 6/11 도착)
- 최대 적립
- ~865
더 보기 & 주문하기
사진

상품 내용
별점 5 (3).
가격 17,300₩.
배송요금 2,500 (수요일 6/11 도착).
최대 적립 ~865₩.
더 보기

- 용량당 가격
- 17,300₩/1
- 가격
- 17,300₩
- 별점
- 4.5

- 가격
- 12,000₩
- 별점
- 5.0

- 용량당 가격
- 15,400₩/1
- 가격
- 15,400₩
- 별점
- 4.5

- 용량당 가격
- 10,500₩/1
- 가격
- 10,500₩
- 별점
- 4.5

- 용량당 가격
- 17,300₩/1
- 가격
- 17,300₩
- 별점
- 5.0

- 가격
- 17,300₩
- 별점
- 0.0

- 가격
- 17,300₩
- 별점
- 5.0

- 용량당 가격
- 5,300₩/1
- 가격
- 5,300₩
- 별점
- 5.0

- 용량당 가격
- 17,280₩/1
- 가격
- 17,280₩
- 별점
- 0.0

- 용량당 가격
- 16,340₩/1
- 가격
- 16,340₩
- 별점
- 0.0

- 용량당 가격
- 26,000₩/1
- 가격
- 26,000₩
- 별점
- 5.0

- 가격
- 18,200₩
- 별점
- 0.0

- 가격
- 23,190₩
- 별점
- 5.0

- 용량당 가격
- 26,960₩/1
- 가격
- 26,960₩
- 별점
- 0.0

- 가격
- 13,000₩
- 별점
- 0.0

- 가격
- 16,200₩
- 별점
- 5.0

- 가격
- 17,300₩
- 별점
- 3.5

- 용량당 가격
- 27,000₩/1
- 가격
- 27,000₩
- 별점
- 0.0

- 용량당 가격
- 11,800₩/1
- 가격
- 11,800₩
- 별점
- 5.0

- 가격
- 13,400₩
- 별점
- 0.0
(유료광고) 이 상품은
쿠팡 파트너스 수수료에서 1~3%를 제공받습니다.